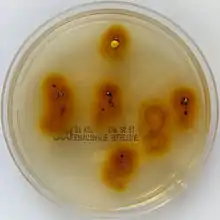

Trichophyton tonsurans
Trichophyton tonsurans é um fungo antropofílico da família Arthrodermataceae que causa dermatofitose no couro cabeludo (tinea capitis). Pode ser encontrado no mundo inteiro, mas é mais comum no nordeste brasileiro, México, EUA e África. Afeta principalmente crianças e é responsável por diversas epidemias de tinha do couro cabeludo em escolas e creches.[1]
| Trichophyton tonsurans | |
|---|---|
| |
| Trichophyton tonsurans em um ágar seletivo para dermatófitos. | |
| Classificação científica | |
| Reino: | |
| Divisão: | |
| Classe: | |
| Ordem: | |
| Família: | |
| Gênero: | |
| Espécies: | T. tonsurans |
| Nome binomial | |
| Trichophyton tonsurans Malmsten (1848) | |

Colônias
Em ágar Sabouraud dextrose as colônias tendem a ser planas, com um centro elevado, de crescimento lento, amarelada-pálida ou parda por cima e avermelhada por baixo, liberando um pó pigmentado espalhado pelo ágar. Eventualmente pode ficar mais branca e com dobras. Não é fluorecente com lâmpada de Wood.[2]
As hifas são relativamente amplas, irregulares, muito ramificadas com numerosos septos. Numerosos macroconídios característicos variam em tamanho e forma de longa clavada a ampla piriforme, formando ângulo reto com as hifas, que muitas vezes permanecem não coradas pelo azul do lactofenol.[2]
Patologia
Causa perda de cabelo na cabeça ou no corpo, principalmente em crianças. Algumas pessoas podem ser transmitido por portadores assintomáticos e transmitirem o fungo aos outros. Também pode causar onicomicose (micose na unha) e tinea pedis(pé de atleta). Pode ser tratado e prevenido com xampu antifúngico.[3]
Referências
- Sidrim, JJ; Rocha, MF; Leite, JJ; Maranhão, FC; Lima, RA; Castelo-Branco Dde, S; Bandeira Tde, J; Cordeiro Rde, A; Brilhante, RS (November 2013). "Trichophyton tonsurans strains from Brazil: phenotypic heterogeneity, genetic homology, and detection of virulence genes". Canadian journal of microbiology 59 (11): 754–60. doi:10.1139/cjm-2013-0670. PMID 24206358.
- Adelaide University - Mycology Online - T.tonsurans
- Rebell, Gerbert; Taplin, David; Blank, Harvey (1964). Dermatophytes Their Recognition and Identification. Miami, FL: Dermatology Foundation of Miami.